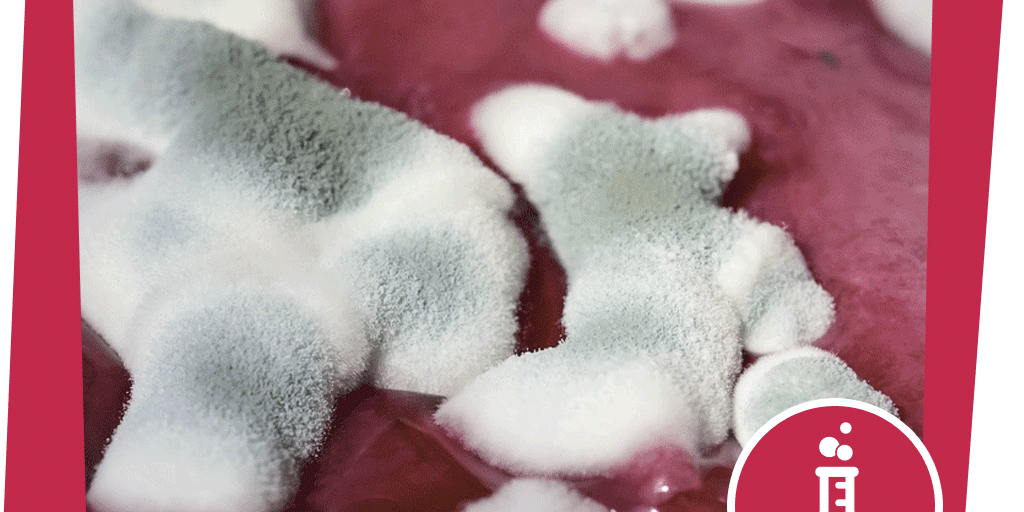

Experiment:
Deine Schimmelpilz-Zucht im Glas

© Pixabay | bogitw
Schimmelpilze sind Pilze, die Pilzfäden und winzig kleine Sporen ausbilden. Die Sporen kannst du mit dem bloßen Auge nicht sehen, sondern nur unter einem Mikroskop. Sie helfen mit, organisches Material zu zersetzen und sind daher wichtig für den Kreislauf in der Natur. Die Sporen von Schimmelpilzen fliegen eigentlich überall in der Luft herum, sind aber auch im Boden. Bei Trockenheit können sie über Monate und Jahre überleben. Wachsen können sie nur, wenn es feucht ist. Züchte deine eigene Schimmelpilz-Kultur!
Du brauchst:
- ein Marmeladenglas
- ein kleines Stückchen von einer dünnen Scheibe Brot
- ein bisschen Wasser
- eine Pipette
- Filterpapier
- Klebeband
Und so wird’s gemacht:
- Tropfe mit der Pipette so viel Wasser in dein Glas, bis der Boden mit Wasser benetzt ist.
- Lege das Brot hinein.
- Bedecke das Glas mit dem Filterpapier. Es verhindert, dass sich im Glas Tropfen bilden, da es sie direkt aufsaugt.
- Schraube das Glas zu und schneide das überstehende Filterpapier ab.
- Klebe den Deckelrand noch zusätzlich mit Klebeband ab.
- Beobachte was geschieht!